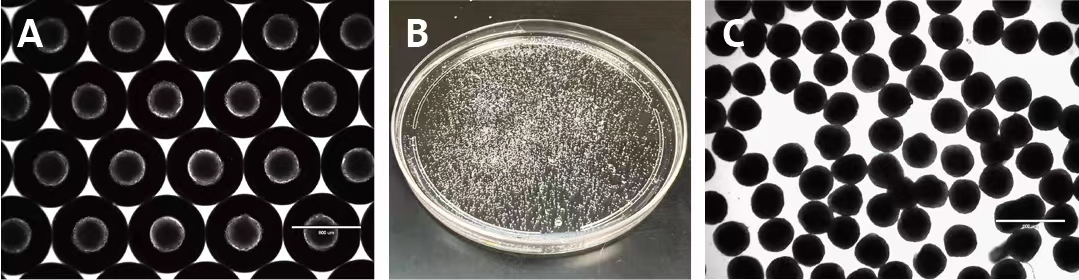
产品细节图片4

万千商家帮你免费找货
0 人在求购买到急需产品
- 详细信息
- 询价记录
- 文献和实验
- 技术资料
Corning® Elplasia® 12K培养瓶——助您轻松培养上万个多细胞球
随着3D细胞培养成功应用于包括抗肿瘤药物筛选和体外肿瘤研究在内的多个领域,研究人员需要更好的方法来生成大量大小均一的多细胞球。
Corning Elplasia 12K培养瓶能够在无支架模型中生成高密度多细胞球,从而满足上述需要。
Corning Elplasia 12K培养瓶每cm²含有152个微腔,体积与T-75培养瓶相当。借助重力、康宁低吸附(ULA)表面以及圆形微腔,可形成约12,000个形状和大小一致的多细胞球。

康宁超低吸附表面是一种专有的无动物源性共价结合水凝胶表面,可促进多细胞球的形成且便于收集。
微腔的几何形状有助于多细胞球在更换培养基时保持原位,收集时不影响细胞回收。细胞瓶内部具有分流功能,能够在移液时尽可能减少对多细胞球的破坏。
Corning Elplasia 12K细胞培养瓶适用于许多肿瘤细胞、正常细胞和原代细胞的3D培养,应用领域广泛,包括:
-
药物筛选
-
癌症/肿瘤生物学
-
干细胞生物学
-
细胞治疗研究
-
3D组织工程
主要特性
-
康宁超低吸附表面
-
光学透明的透气性聚苯乙烯薄膜,自发荧光低
-
液体分流功能可以在更换培养基和操作培养瓶时尽可能降低液体流动的影响
-
80cm²表面积,152个微腔/cm²,每个培养瓶可生成约12,000个大小和形状一致的多细胞球
-
圆形孔底
-
微腔尺寸:850 x 650 μm (顶部直径 x 深度),多细胞球生长面积为500 x 600 μm (直径 x 深度)
-
工作体积为25至50 mL
主要优势
-
便于多细胞球形成、培养、评估和收集
-
提供便捷的“即用型”方案,可生成大量大小均一的多细胞球
-
无支架培养
-
可培养多细胞球长达30天甚至更长时间 (具体取决于细胞系)
-
每个微腔均可形成大量多细胞球,具有高度可重复性
-
常用培养基储存瓶,所有多细胞球均处于相同的培养条件下
-
与明场显微镜和荧光显微镜兼容

Corning®Elplasia® 12K培养瓶可在同一培养条件下生成大量大小均一的多细胞球,提供便捷的“即用型”方案

用Corning Elplasia 12K培养瓶培养并评估过的细胞系
Corning Elplasia 12K培养瓶能够生成大量大小均一的多细胞球。在Corning Elplasia 12K培养瓶中培养14天的MCF 7 (人乳腺癌) 多细胞球 (A)。收集后的多细胞球 (B)。收集的MCF 7多细胞球示意图 (C)。使用EVOS® FL显微镜和2X物镜在明场模式下拍摄显微照片

Corning Elplasia 12K培养瓶基质内含有约12,000个圆底微腔,每个微腔的生长面积为500 x 600 μm (直径 x 深度) 且底部可透气

Corning Elplasia 12K培养瓶适用于荧光成像。用钙黄绿素AM (A)、Hoechst (B) 和碘化丙啶 (C) 染色培养30天的HepG2 (人肝癌) 多细胞球,将A、B和C的明场图像叠加 (D)。使用EVOS FL显微镜和2X物镜拍摄显微照片

Corning Elplasia 12K培养瓶可用于长期培养。在Corning Elplasia 12K培养瓶中培养A-549/GFP (人肺癌)多细胞球30天。使用EVOS FL显微镜和2X物镜在明场和GFP模式下拍摄显微照片
订购信息

风险提示:丁香通仅作为第三方平台,为商家信息发布提供平台空间。用户咨询产品时请注意保护个人信息及财产安全,合理判断,谨慎选购商品,商家和用户对交易行为负责。对于医疗器械类产品,请先查证核实企业经营资质和医疗器械产品注册证情况。
- 作者
- 内容
- 询问日期
 文献和实验
文献和实验Taq Talk 荧光定量 PCR 系列课程之【TaqMan®检测的工作原理】基于 TaqMan®探针法的 qPCR 检测可提供比染料法更好的灵敏度和特异性
Vybrant® DyeCycle Green and Orange Stains
Stability Vybrant® DyeCycle™ Green stain Vybrant® DyeCycle™ Orange stain 400 μL 5 mM solution in dimethyl sulfoxide (DMSO
相关专题 误区:凝胶试剂总是修饰我的蛋白 事实:NuPAGE® 凝胶试剂实际上保护了您的蛋白 更中性pH是关键 tris-甘氨酸凝胶系统的根本缺点是样品制备过程中的蛋白降解。在使用pH 6.8的tris-甘氨酸样品缓冲液时,样品在缓冲液中加热,因tris-甘氨酸的负温度系数导致pH值下降。这最终导致蛋白水解。 NuPAGE® 凝胶试剂通过维持较高的样品缓冲液pH值,保留了蛋白样品的完整
 技术资料
技术资料暂无技术资料 索取技术资料











